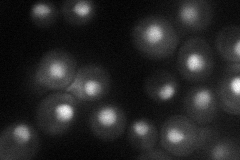
YER045C
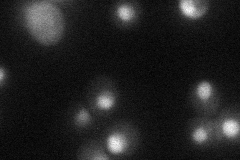
YER045C
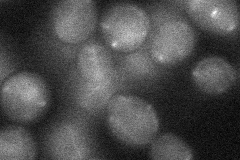
YER045C

View description
Basic leucine zipper (bZIP) transcription factor of the ATF/CREB family, may regulate transcription of genes involved in utilization of non-optimal carbon sources
Localization:
Intensity:
Fold change:
Significance:
-
C’ GFP library in SD

below threshold15.76 -
N' NOP1pr-GFP in SD
nucleus44.0962 -
N' TEF2pr-mCherry in SD
nucleus24.2968 -
N' NATIVEpr-GFP in SD

below threshold19.4881 -
N' TEF2pr-VC and Cyto-VN in SD
below threshold25.4588 -
C’ GFP library in SD+DTT

cytosol17.31.09No -
C’ GFP library in SD+H2O2

cytosol16.481.04No -
C’ GFP library in Starvation Media

cytosol14.210.9No -
C’ GFP library on the background of Pup2-DaMP

below threshold -
C’ GFP library on the background of CCT mutant

below threshold17.24891.0939No
